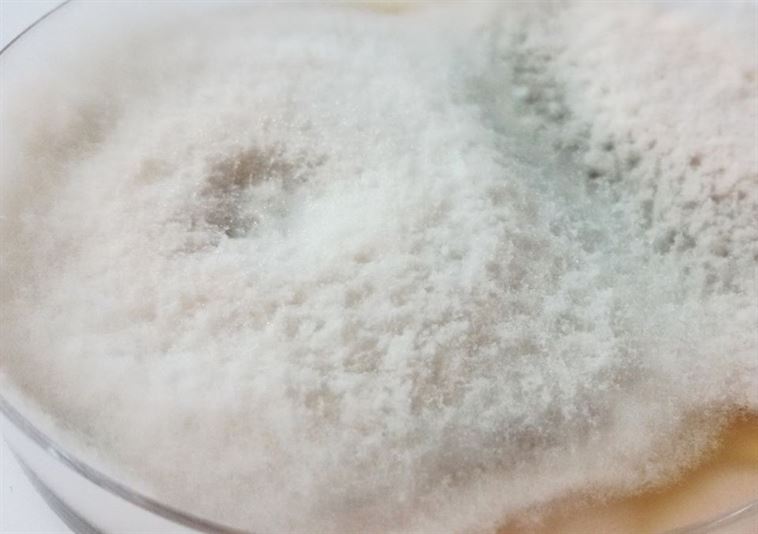

הילה שרעבי, בוגרת לימודי עיצוב ב-HIT שבחולון, יצרה את הפרויקט mustone, העוסק במחקר טקסטורות ופאטרנים מרהיבים, הנוצרים דווקא מעובשים מצולמים ומודפסים על גבי אריחי אבן וקרמיקה.

העובש עובר תהליך עיבוד בשליטת המעצבת בתנאי מעבדה, כדי להגיע לתוצאה הרצויה. את התהליך מתארת המעצבת כ"דיאלוג בין שליטת המעצב לתהליכים טבעיים. יחס עדין בין תהליכים של קלייה ושימור, הקפאת הזמן ברגע גסיסת החומר האורגני. הענקת חיי נצח לרגע הפירוק והתמרה של חומר ממזון לריקבון. החקירה כללה טסטים הקשורים בתהליך הריקבון עד התוצר הסופי המתייחס לחומריות, טקסטורה, קומפוזוציה, צבעוניות. נבדק תהליך ריקבון של חומרים אורגניים שונים. והדפסות על אריחים וסוגי אבן מגוונים המוצר מחדש ומעשיר את עולם הטקסטורות והצבעים ונותן למעצב אפשרויות אינסופיות. מקורות ההשראה שלי באו מהמקום לתעד שלבי פירוק וריקבון, היופי והאסטתיקה שבמכוער בתהליכים טבעיים של הטבע".
הפרויקט הוגש לתחרות "אות העיצוב 2015" והגיע לשלב הגמר.